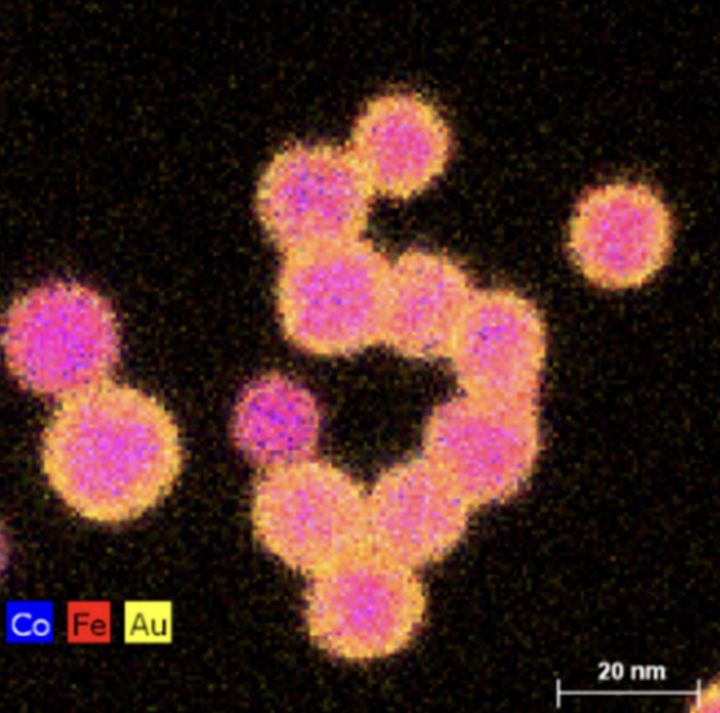
project 1

Functional Nanoparticles
One area of research within SAMPL is in the structure and properties of novel nanoparticles formed via inert gas condensation (IGC). With this technique, we can form monodispersed nanoparticles with sizes ranging from a few nanometers to tens of nanometers. IGC allows the formation of far-from-equilibrium structures, such as complete or extended solid solutions in normally immiscible systems, and these structures can then be pathways to other atomic arrangements, such as chemically ordered compounds, which are hidden by bulk equilibrium conditions. IGC can also effectively form equilibrium compounds which are challenging to form via other techniques. An example is WFe2 (and other Laves phases); the vast differences in melting temperatures often lead to large peritectic regions. The resultant segregation during melt processing is virtually impossible to eliminate. We have generally focused on exploring new magnetic materials through this research.
We can also design core/shell and core/frame structures, with many potential applications dependent upon the core and shell materials. One direction we have explored is creating metal A/ metal B oxide core/shell structures, with the metal oxide displaying resistive switching characteristics. When the nanoparticles are assembled into a device, a biorealistic synapse is formed, with important ramifications for neuromorphic computing.

Related Publications:
- Z. Ahmadi, H. Lu, P. Mukherjee, M. Koten, A. Gruverman, and J. E. Shield, “Resistive Switching in Individual Co/ZnO Core/Shell Nanoparticles Formed via Inert Gas Condensation and Selective Oxidation,” Adv. Elect. Mater. 6, 2000065 (2020).
- M.A. Koten, S.A. Voeller, M.M. Patterson and J.E. Shield, “In situ measurements of plasma properties during gas-condensation of Cu nanoparticles,” J. Appl. Phys. 119, 14306 (2016).
- P. Mukherjee, B. Balamurugan, J.E. Shield and D.J. Sellmyer, “Direct gas-phase formation of complex core-shell and three-layer Mn-Bi nanoparticles,” RSC Advances 6, 92765-92770 (2016) (DOI: 10.1039/c6ra15799h).
- M.A. Koten, P. Mukherjee and J.E. Shield, “Core-Shell Nanoparticles Driven by Surface Energy Differences in the Co-Ag, W-Fe and Mo-Co Systems,” Part. Part. Syst. Charact. 32, 848-853 (2015). (DOI: 10.1002/ppsc.2201500010).
- M.A. Koten, P. Manchanda, B. Balamurugan, R. Skomski, D.J. Sellmyer and J.E. Shield, “Ferromagnetism in Laves-phase WFe2nanoparticles,” APL Mat. 3, 076101 (2015).
- P. Mukherjee, Priyanka Manchanda, Pankaj Kumar, Lin Zhou, M. J. Kramer, Arti Kashyap, Ralph Skomski, D. J. Sellmyer, and J. E. Shield, “Size-induced Chemical and Magnetic Ordering in Individual Fe-Au Nanoparticles,” ACS Nano 8, 8113-8120 (2014).
- P. Mukherjee, X. Jiang, Y. Wu, M.J. Kramer and J.E. Shield, “Nucleation-suppressed phase stabilization in nanoclusters,” J. Phys. Chem. C 117, 24071-24078 (2013).
- P. Mukherjee, Lin Zhou, M. J. Kramer, and J. E. Shield, “Formation of non-equilibrium solid solutions in nanoclusters,” Appl. Phys. Lett. 102, 243103 (2013).
- F. Golkar, M.J. Kramer, R. Skomski, D.J. Sellmyer and J.E. Shield, “Solubility Extension and Phase Formation in Gas-Condensed Co-W Nanoclusters,” J. Nanopart. Res. 15, 1638 (2013).
- E. Folcke, J.M. Le Breton, W. Lefebvre, J. Bran, R. Lardé, F. Golkar, J. E. Shield, “Investigation of the magnetic properties of FeAu nanoclusters in a W matrix: evidence for exchange-bias phenomenon,” J. Appl Phys. 113, 183903 (2013).
- P. Mukherjee, Y. Zhang, M.J. Kramer, L.H. Lewis and J.E. Shield, “L10 Structure Formation in Slow-cooled Fe-Au Nanoclusters,” Appl. Phys. Lett. 100, 222405 (2012).
- F. Golkar, M.J. Kramer, Y. Zhang, R.W. McCallum, R. Skomski, D.J. Sellmyer and J.E. Shield, “Structure and Magnetic Properties of Co-W Clusters Produced by Inert Gas Condensation,” J. Appl. Phys. 111, 07B524 (2012).
- E. Folcke, R. Lardé, J.M. Le Breton, M. Gruber, F. Vurpillot, J.E. Shield, X. Rui, M.M. Patterson, “Laser-assisted atom probe tomography investigation of magnetic FePt nanoclusters: First experiments,” Journal of Alloys and Compounds 517, 40-44 (2012).
- X. Rui, Z. Sun, R. Skomski, Y. Xu, D.J. Sellmyer, Y.Q. Wu, M.J. Kramer and J.E. Shield, “Intra-cluster Exchange-coupled High-Performance Permanent Magnets,” J. Magn. Magn. Mater. 320, 2576 (2008).
Additive Manufacturing
One area of SAMPL is additive manufacturing (AM)—metal 3D printing. This materials processing/manufacturing route offers design flexibility that can revolutionize countless industries. Parts unable to be built by conventional processing can be manufactured, offering weight savings and added shape complexity which can significantly reduce the total number of parts in a machine. Biomedical implants can be personalized, aircraft can be made differently, and electric motors can be more efficient. The challenge in AM is part-to-part—and even region-to-region—reproducibility to ensure performance.
The work in SAMPL seeks to tie the microstructural evolution to AM process conditions. Since the microstructural evolution is intimately tied to the thermal solidification conditions, we are collaborating with heat transfer experts who are building models to predict the thermal history of parts, position by position. We use a variety of microscopic techniques examine the microstructural evolution and correlate these to both thermal models and sensor data, with the goal to confirm accuracy of the models as well as connect specific sensor signals to microstructural features.
A second thrust in the AM research within SAMPL is to develop AM processing for permanent magnet materials. This leverages our long history of working in permanent magnets with growing expertise in AM. AM of functional materials is in its infancy, and for permanent magnets is especially challenging considering how sensitive magnetic performance is on the microstructure. However, the reduction in material waste and design flexibility offer distinct advantages and great potential impact. Future efforts in this area includes multimaterial printing to fabricate the stator or rotor with embedded permanent magnets.




Related Publications:
- Z. Smoqi, B.D. Bevans, A. Gaikwad, J. Craig, A. A
bul-Haj, B. Roeder, B. Macy, J.E. Shield and P.K. Rao, “Closed-loop control of meltpool temperature in directed energy deposition,” Materials & Design 215, 110508 (2022). - Z. Smoqi, J.Toddy
- , H.S. Halliday, J. E. S
hield, P.K. Rao, “Process-Structure Relationship in the Directed Energy Deposition of Cobalt-Chromium Alloy (Stellite 21) Coatings,” Materials & Design 197, 109229 (2020). - W. Zhang, S. Valloppilly, X.Z. Li, L. Yue, R. Skomski, I.E. Anderson, M.J. Kramer, W. Tang, J. Shield, and D.J. Sellmyer, “Texture development and coercivity enhancement in cast alnico 9 magnets,” AIP Advances 8, 056215 (2018).
- N. R. Overman, X. Jiang, R. K. Kukkadapu, T. Clark, T.J. Roosendaal, G. Coffey, J.E. Shield and S.N. Mathaudhu, “Physical and electrical properties of melt-spun Fe-Si (3-8 wt.%) soft magnetic ribbons,” Mater. Charact. 136, 212-220 (2018).
- L. Zhang, M. Wang, X. Yan, Y. Lin and J.E. Shield, “Effect of low-melting point phases on the microstructure and properties of spark plasma sintered and hot deformed Nd-Fe-B alloys,” J. Magn. Magn. Mater. 452, 483-487 (2018).
Laser Surface Processing
Femtosecond laser surface processing (FLSP) offers a unique route to creating functionalized surfaces for a wide variety of applications. FLSP transforms nominally smooth surfaces to have micro-scale surface structures. From a materials perspective, the goal is to understand the surface structure formation mechanisms and ultimately a map of the structure-processing relationships. One key that has greatly furthered our understanding of the processes is the ability to examine the subsurface microstructures using focused ion beam (FIB) milling of individual mounds and base material in the vicinity of the surface features. Scanning electron micrographs combined with elemental analysis using energy dispersive x-ray spectroscopy provide insight in the thermal excursions and phase transformations that occur during FLSP. We can determine if the formation mechanism is more subtractive (e.g., ablative) or a rearrangement of material via incipient melting, fluid flow, and solidification. Re-deposition of ablated material also occurs and can be analyzed. Subsurface structures have provided significant insight into material performance as well. Under some processing conditions, alternating layers of the base metal and its metal oxide form. These submicron layers can significantly affect heat transfer characteristics, for example. Ultimately, the goal is to design specific surface structure characteristics to maximize performance for a given application.


Related Publications
- A. Reicks, A. Tsubaki, M. Anderson, J. Wieseler, L. Khosravi Khorashad, J.E. Shield, G. Gogos, D.R. Alexander, C. Argyropoulos and C.A. Zuhlke, “New-unity broadband omnidirectional emissivity via femtosecond laser surface processing,” Commun. Mater. 2, 36 (2021).
- Mark Anderson, Justin Costa-Greger, Aaron Ediger, Craig Zuhlke, Dennis Alexander, George Gogos, Jeffrey E Shield, “Heat transfer behavior of as-processed and cleaned picosecond pulse laser processed copper,” Therm. Sci. Eng. Progress 27, 101105 (2021).
- M. Anderson, A. Ediger, A. Tsubaki, C.A. Zuhlke, D.A. Alexander, G. Gogos and J.E. Shield, “Surface and microstructure investigation of picosecond versus femtosecond laser pulse processed copper,” Surf. And Coatings 409, 126872 (2021).
- E. Peng, A. Roth, C.A. Zuhlke, S. Azadehranjbar, D.R. Alexander, G. Gogos and J.E. Shield, “3D electron microscopy characterization of Ag mound-like structures made by femtosecond laser surface processing,” Appl. Surf. Sci. 480, 1047 (2019).
- Y.X. Song, A. Tsubaki, C. Zuhlke, E. Rezaei, G. Gogos, D.R. Alexander, and J.E. Shield, “Effect of topology and material properties on the imprint quality of the femtosecond laser-induced surface structures,” J. Mater. Sci. 53, 3836-3845 (2018).
- E. Peng, R. Bell, C.A. Zuhlke, M.Y. Wang, D.R. Alexander, G. Gogos and J.E. Shield, “Growth mechanisms of multiscale, mound-like surface structures on titanium by femtosecond laser processing,” J. Appl. Phys. 122, 133108 (2017).
- E. Peng, A. Tsubaki, C.A. Zuhlke, M. Wang, R. Bell, M.J. Lucis, T.P. Anderson, D.R. Alexander, G. Gogos and J.E. Shield, “Micro/Nanostructures formation by femtosecond laser surface processing on amorphous and polycrystalline Ni60Nb40,” Appl. Surf. Sci. 396, 1170-1176 (2017).
- E. Peng, A. Tsubaki, C.A. Zuhlke, M. Wang, R. Bell, M.J. Lucis, T.P. Anderson, D.R. Alexander, G. Gogos and J.E. Shield, “Experimental explanation of the formation mechanism of surface mound structures by femtosecond laser on polycrystalline Ni60Nb40,” Appl. Phys. Lett. 108, 031602 (2016).